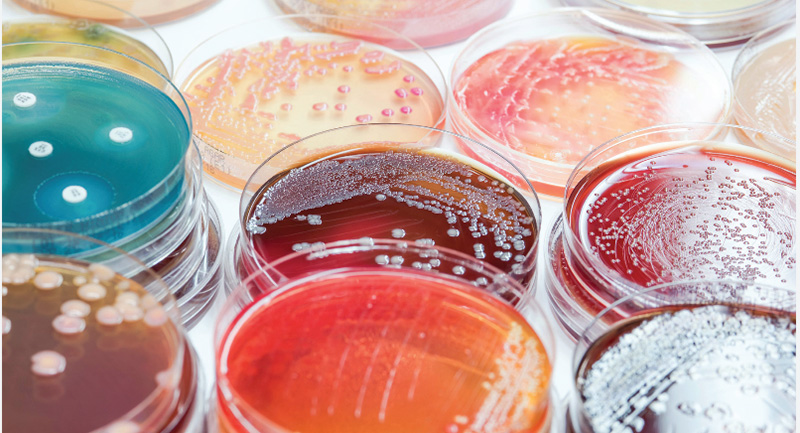
产品一.jpg

作为食品安全技术领域规模最大、人气最旺和最受欢迎的行业盛会之一,CBIFS第十八届食品安全技术论坛暨太平洋食安展将于2026年4月9日-10日在苏州举办。
河南海美迪生物确认参展本次论坛,欢迎各位领导专家和客户朋友参观交流、合作洽谈!


河南海美迪生物技术有限公司
河南海美迪生物技术有限公司是一家专业从事微生物检测产品的公司。
公司以经营进口微生物检测产品为主要业务,产品涵盖食品微生物、临床微生物和制药微生物三大领域。自成立以来,海美迪生物以“诚信服务”为核心,目前是印度HIMEDIA、意大利Liofilchem品牌的中国区总代理。
公司主营产品为:ChroMogenic显色培养基、维生素测定培养基、微生物生化鉴定试剂盒、DCM脱水培养基、测试片等产品。
企业宗旨:
互相尊重,忠于海美迪事业
诚信服务,以质量为根本
拼搏创新,专业于微生物产品
地址:河南省濮阳市濮阳县铁丘路中稹绿探工业园区3号楼
网址:http://www.huafubio.com/

- 扫码关注公众号 -
ChroMogenic显色培养基
河南海美迪生物显色培养基产品包括沙门氏菌显色培养基、OA单增李斯特菌显色培养基、金黄色葡萄球菌显色培养基、弧菌显色培养基、克罗诺肠杆菌显色培养基、TBX显色培养基、STEC显色培养基、乳酸杆菌显色培养基等。
食品,水,环境,临床

维生素测定培养基
河南海美迪生物维生素测定产品包括B12测定用培养基、叶酸酪蛋白培养基、泛酸测定用培养基 、烟酸测定用培养基、乳酸杆菌琼脂、乳酸杆菌肉汤等。
乳制品、食品

生化鉴定试剂盒
河南海美迪生物生化鉴定试剂盒(比色法)包括肠杆菌科、沙门氏菌、葡萄球菌、链球菌、革兰氏阴性菌等试剂盒套盒,试剂盒微孔中包含细菌生化鉴定实验的各种培养基和显色剂和各种辅助试剂,不需要单独购买其他配套试剂。
食品,水,环境

DCM脱水培养基
河南海美迪生物DCM脱水培养基包括BPW、XLD 、VRBA、VRBGA、PCA、孟加拉红等培养基。产品分为动物源、植物源、颗粒型、化学限定型四种形式,可满足客户的需求。
食品,制药、临床

HiRapid™微生物测试片
河南海美迪生物技术有限公司微生物测试片产品包括菌落总数测试片(RAC)、大肠菌群测试片(RCC)、金黄色葡萄球菌测试片(STX)、霉菌酵母菌测试片(YM)。
食品、水、环境




